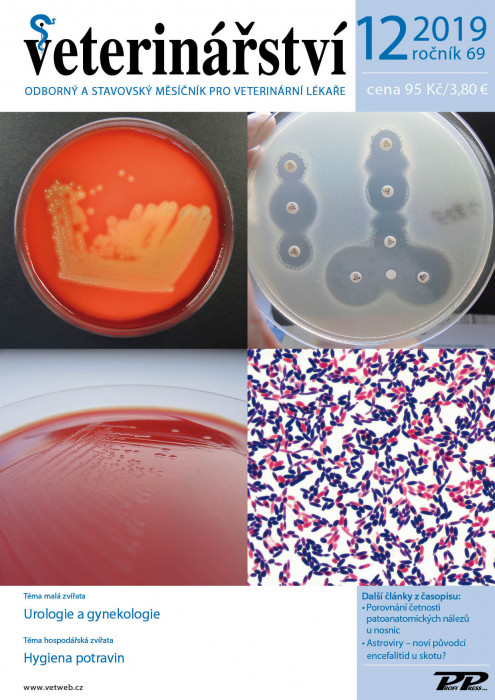
Obálka titulu Veterinářství - vydání č. 12/2019

Veterinářství Odborný a stavovský měsíčník pro veterinární lékaře
Skupina: Veterinární medicína, ISSN: 0506-8231Počet stran 68 – 72
Cena na stánku 95 Kč
Vydání za rok 12 vydání
Vychází od roku 1951
Varianty předplatného
Popis
Odborný veterinární měsíčník určený všem praktickým veterinárním lékařům v ČR i SR. Časopis je rozdělen v poměru odpovídajícím požadavkům čtenářů na stálé rubriky, kterými jsou malá zvířata a hospodářská zvířata, včetně koní. Další část odborných rubrik zahrnuje témata exotických zvířat, hygieny potravin, drůbeže a volně žijících zvířat. Informační servis, management, legislativa a přehled nově registrovaných veterinárních léčiv doplňují komplexnost časopisu tak, aby byl nepostradatelným pro každého veterinárního lékaře. Časopis má významné zastoupení u čtenářů ve Slovenské republice a byl zařazen mezi odborné recenzované časopisy.
Archiv elektronických vydání
- Téma: Zdravotní problematika drobných savců
- Nemoci ryb a včel
- Téma: Intoxikace
- Poruchy metabolismu; Drůbež
- Téma: Dermatologie
- Drůbež
- Téma:
- Infekční nemoci a parazitologie
- Nemoci koní
- Téma: Klinická výživa a gastroenterologie
- Nemoci prasat
- Téma: Nemoci koček
- Nemoci mláďat přežvýkavců
- Téma: Urologie, gynekologie a andrologie
- Hygiena potravin; Welfare
- Téma: Chirurgie
- Welfare
- Téma: Infekční nemoci
- Nemoci skotu a mastitidy
- Téma: Akutní medicína, anestezie
- Nemoci koní
- Téma: Interní medicína
- Nemoci prasat
- Téma: Laboratorní a klinická diagnostika
- Zdravotní problematika ovcí a koz
- Téma: Zdravotní problematika drobných savců
- Nemoci lovné zvěře, ryb a včel
- Téma: Intoxikace
- Poruchy metabolismu a reprodukce
- Téma: Dermatologie
- Drůbež a králíci
- Téma: Infekční nemoci a parazitologie
- Nemoci koní
- Téma: Klinická výživa a gastroenterologie
- Nemoci prasat
- Téma: Nemoci koček
- Nemoci zvířat v zájmových chovech a zoozvířat
- Téma: Gynekologie
- Hygiena potravin
- Téma:
- Chirurgie
- Welfare
- Téma: Urologie
- Zdravotní problematika hospodářských zvířat
- Téma: Akutní medicína
- Nemoci koní
- Téma:
- Interní medicína
- Nemoci prasat
- Téma: Laboratorní a klinická diagnostika
- Zdravotní problematika ovcí a koz
- Téma: Zdravotní problematika drobných savců
- Choroby ryb
- Téma:
- Intoxikace
- Poruchy metabolismu a reprodukce
- Téma:
- Dermatologie
- Drůbež a králíci
- Téma:
- Infekční nemoci a parazitologie
- Nemoci koní
- Téma: Klinická výživa a gastroenterologie
- Nemoci prasat
- Téma:
- Nemoci koček
- Nemoci mláďat přežvýkavců
- Téma:
- Urologie, gynekologie a andrologie
- Hygiena potravin
- Téma:
- Chirurgie a zobrazovací techniky
- Welfare
- Téma:
- Hematologie
- Nemoci skotu a mastitidy
- Téma: Akutní medicína, anestezie
- Nemoci koní, mastitidy
- Téma:
- Interní medicína, neurologie
- Nemoci prasat
- Téma:
- Laboratorní a klinická diagnostika
- Zdravotní problematika ovcí a koz
- Téma:
- Zdravotní problematika drobných savců
- Choroby lovné zvěře, ryb a včel
- Téma: Intoxikace a welfare
- Poruchy metabolismu a reprodukce
- Téma:
- Dermatologie
- Drůbež a králíci
- Téma: Infekční nemoci a parazitologie
- Nemoci koní
- Téma:
- Klinická výživa a gastroenterologie
- Nemoci prasat
- Téma:
- Nemoci koček
- Nemoci mláďat přežvýkavců
- Téma: Urologie, gynekologie, andrologie
- Hygiena potravin
- Téma: Chirurgie a zobrazovací techniky
- Welfare
- Nemoci psů a koček
- Nemoci skotu a mastitidy
- Akutní medicína
- Nemoci koní
- Malá zvířata: Interní medicína
- Hospodářská zvířata: Nemoci prasat
- Malá zvířata: Laboratorní a klinická diagnostika
- Hospodářská zvířata: Zdravotní problematika ovcí a koz
- Malá zvířata: Zdravotní problematika drobných savců
- Hospodářská zvířata: Choroby ryb a včel
- Téma:
- Anestezie
- Poruchy metabolismu a reprodukce
- Téma:
- Dermatologie
- Drůbež a králíci
- Téma: Infekční nemoci a parazitologie
- Nemoci koní
- Malá zvířata: Klinická výživa a gastroenterologie
- Hospodářská zvířata: Nemoci prasat
- Malá zvířata: Nemoci koček
- Hospodářská zvířata: Nemoci přežvýkavců
- Malá zvířata: Urologie, gynekologie a andrologie
- Hospodářská zvířata: Hygiena potravin
- Malá zvířata: Hematologie
- Hospodářská zvířata: Welfare a zoohygiena
- Malá zvířata: Hematologie a imunologie
- Hospodářská zvířata: Nemoci skotu a mastitidy
- Malá zvířata: Gastroenterologie psů a koček
- Hospodářská zvířata: Nemoci koní
- Malá zvířata: Interní medicína
- Hospodářská zvířata: Nemoci prasat
- Laboratorní a klinická diagnostika
- Zdravotní problematika ovcí a koz
- Téma malá zvířata: Chirurgie
- Téma hospodářská zvířata: Nemoci ryb a včel
- Téma: Intoxikace
- Poruchy metabolismu a reprodukce
- Malá zvířata: Dermatologie
- Hospodářská zvířata: Drůbež a králíci
- Malá zvířata: Infekční nemoci a parazitologie
- Hospodářská zvířata: Nemoci koní
- Téma: Klinická výživa a gastroenterologie
- Nemoci prasat
- Téma malá zvířata: Nemoci koček a psů
- Téma hospodářská zvířata: Nemoci přežvýkavců
- Téma malá zvířata: Urologie, gynekologie, andrologie
- Téma hospodářská zvířata: Hygiena potravin
- Téma malá zvířata: Chirurgie a zobrazovací techniky
- Téma hospodářská zvířata: Welfare
- Téma malá zvířata: Hematologie
- Téma hospodářská zvířata: Nemoci skotu a mastitidy
- Téma malá zvířata: Akutní medicína, anestezie
- Téma hospodářská zvířata: Nemoci koní
- Téma malá zvířata: Stomatologie
- Téma hospodářská zvířata: Nemoci prasat
- Téma malá zvířata: Laboratorní a klinická diagnostika
- Téma hospodářská zvířata: Zdravotní problematika ovcí a koz
- Téma malá zvířata: Zdravotní problematika drobných savců
- Téma hospodářská zvířata: Choroby včel
- Téma malá zvířata: Intoxikace
- Téma hospodářská zvířata: Poruchy metabolismu a reprodukce
- Téma malá zvířata: Dermatologie
- Téma hospodářská zvířata: Drůbež, králíci
- Téma malá zvířata: Infekční nemoci a parazitologie
- Téma hospodářská zvířata: Nemoci koní
- Téma malá zvířata: Klinická výživa a gastroenterologie
- Téma hospodářská zvířata: Nemoci prasat
- Další články z časopisu: Anomálie cerebellopontinní oblasti psů – popis dvou případů
- Výsledky sledování rezistencí izolátů Streptococcus suis k antimikrobikům v roce 2019
- Téma malá zvířata: Nemoci mláďat. Téma hospodářská zvířata: Nemoci přežvýkavců. Další články z časopisu: Charakteristika a produkce vybraných druhů tuňáků a metody identifikace ryb. 100. výročí zahájení výuky
- na VFU Brno.
- Téma malá zvířata: Urologie a gynekologie
- Téma hospodářská zvířata: Hygiena potravin
- Další články z časopisu: Porovnání četnosti patoanatomických nálezů u nosnic
- Astroviry – noví původci encefalitid u skotunull
- Téma malá zvířata: Chirurgie a zobrazovací techniky
- Téma hospodářská zvířata: Welfare, zoohygiena v chovu hosp
- zvířat
- Další články z časopisu: Dietetické možnosti ovlivnění chování psů a koček
- Návykové látky ve veterinární péči
- Téma malá zvířata: Intoxikace, akutní medicína
- Téma hospodářská zvířata: Nemoci prasat
- Další články z časopisu: Nové formy osteochondrózy ramenního kloubu psanull Cirkovirové infekce prasat – způsoby imunoprofylaxe
- Téma malá zvířata: Laboratorní a klinická diagnostika
- Téma hospodářská zvířata: Nemoci koní, mastitidy
- Další články z časopisu: Trombocytární indexy – víc než jen zkratky v hemogramu
- Vliv výživy na zdraví a vitalitu včel (Apis mellifera)
- Téma malá zvířata: Nemoci koček
- Téma hospodářská zvířata: Nemoci skotu
- Další články z časopisu: Nekróza rohovky perských koček – možnosti léčby
- Rodokmenová analýza kongenitální vady skotu – atresia ani et recti
- Téma malá zvířata: Kardiologie. Téma hospodářská zvířata: Choroby lovné zvěře, ryb a včel. Další články z časopisu: Antimikrobiální aktivita propolisu. Bachorová motoličnatost –
- paramfistomatóza přežvýkavců.
- Téma malá zvířata: Nemoci uší psů a koček
- Téma hospodářská zvířata: Poruchy metabolismu a reprodukce skotu
- Další články z časopisu: Srovnání incidence lentivirových infekcí u ovcí a koz s rozdílným genotypem genu transmembránového proteinu TMEM154
- Téma malá zvířata: Klinická výživa a gastroenterologie
- Další články z časopisu: Charakterizace izolátů z koliinfekcí drůbeže v ČR
- Téma malá zvířata: Dermatologie
- Téma hospodářská zvířata: Drůbež, králíci
- Další články z časopisu: Diferenciální diagnostika pruritu u psa
- Probiotika a střevní mikroflóra drůbeže
- Téma malá zvířata: Infekční nemoci a parazitologie.
- Téma hospodářská zvířata: Nemoci prasat.
- Téma malá zvířata: Nemoci drobných savců
- Téma hospodářská zvířata: Nemoci koní
- Další články z časopisu: Cholestáze s obstrukcí biliárního traktu u fretky
- Primoinfekce hříbat gamaherpesviry koní
- EHV-2 a EHV-5 na území ČR
- Téma malá zvířata: Chirurgie, ortopedie
- Téma hospodářská zvířata: Zdravotní problematika ovcí a koz
- Další články z časopisu: Paradoxní vestibulární syndrom u psa
- Zoonózy – nemoci společné lidem a zvířatům
- Téma malá zvířata: Urologie
- Téma hospodářská zvířata: Hygiena potravin
- Téma malá zvířata: Nemoci koček.
- Téma hospodářská zvířata: Welfare, zoohygiena v chovu hospodářských zvířat.
- Téma malá zvířata: Intoxikace, akutní medicína. Téma hospodářská zvířata: Nemoci koní. Další články z časopisu:
- Leiomyosarkom vaječníku u fretky. Spánek a poruchy spánku u koní.
- Téma malá zvířata: Endokrinologie. Téma hospodářská zvířata: Nemoci prasat. Další články z časopisu:
- • Charakteristika mitrální chlopně zobrazené pomocí M-módu při různých onemocněních srdce.
- Téma malá zvířata: Výživa a gastroenterologie. Onkologie.
- Další články z časopisu: Vakcinace malých přežvýkavců proti klíšťové encefalitidě. Mykotoxikózy hydiny.
- Téma malá zvířata: Laboratorní a klinická diagnostika
- Téma hospodářská zvířata: Choroby lovné zvěře, ryb a včel
- Další články z časopisu: Identifikace masa tuňáků v konzervách metodou real-time PCR
- Téma malá zvířata: Kardiologie
- Téma hospodářská zvířata: Poruchy metabolismu skotu
- Další články z časopisu: Vedení porodu psa a kočky – radost, nebo problémnull Subklinická endometritida u krav
- Téma malá zvířata: Nové operační techniky, kazuistiky
- Téma hospodářská zvířata: Infekční onemocnění
- Další články z časopisu: Základy diagnostiky artrotického ochorenia kolena u morčiat
- Případ asymptomatické formy infekční metritidy koní u klisny v okrese Hodonín
- Téma malá zvířata: Dermatologie
- Téma hospodářská zvířata: Drůbež, králíci
- Další články z časopisu: Pododermatitida a dermatitida u králíka
- Hustota osazení haly a úhyn brojlerových kuřat
- Téma malá zvířata: Parazitologie
- Téma hospodářská zvířata: Nemoci prasat
- Další články z časopisu: Mikrobiální kontaminace jatečně upravených těl
- Státní veterinární správa a problematika zoonóz
- Téma malá zvířata: Infekční nemoci, vakcinologie
- Téma hospodářská zvířata: Nemoci koní
- Další články z časopisu: Popis dvou případů spontánního pneumotoraxu u psa a kočky
- Rychlá detekce životaschopného původce paratuberkulózy metodou phage assay